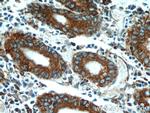
PDIA6 Antibody in Immunohistochemistry (Paraffin) (IHC (P))
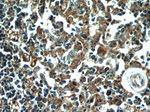
PDIA6 Antibody in Immunohistochemistry (Paraffin) (IHC (P))

Search
Proteintech
PDIA6 Polyclonal Antibody
{{$productOrderCtrl.translations['antibody.pdp.commerceCard.promotion.promotions']}}
{{$productOrderCtrl.translations['antibody.pdp.commerceCard.promotion.viewpromo']}}
{{$productOrderCtrl.translations['antibody.pdp.commerceCard.promotion.promocode']}}: {{promo.promoCode}} {{promo.promoTitle}} {{promo.promoDescription}}. {{$productOrderCtrl.translations['antibody.pdp.commerceCard.promotion.learnmore']}}
产品信息
18233-1-AP
种属反应
已发表种属
宿主/亚型
分类
类型
抗原
偶联物
形式
浓度
规格
纯化类型
保存液
内含物
保存条件
运输条件
产品详细信息
This antibody is specific to PDIA6.
Immunogen sequence: MALLVLGLV SCTFFLAVNG LYSSSDDVIE LTPSNFNREV IQSDSLWLVE FYAPWCGHCQ RLTPEWKKAA TALKDVVKVG AVDADKHHSL GGQYGVQGFP TIKIFGSNKN RPEDYQGGRT GEAIVDAALS ALRQLVKDRL GGRSGGYSSG KQGRSDSSSK KDVIELTDDS FDKNVLDSED VWMVEFYAPW CGHCKNLEPE WAAAASEVKE QTKGKVKLAA VDATVNQVLA SRYGIRGFPT IKIFQKGESP VDYDGGRTRS DIVSRALDLF SDNAPPPELL EIINEDIAKR TCEEHQLCVV AVLPHILDTG AAGRNSYLEV LLKLADKYKK KMWGWLWTEA GAQSELETAL GIGGFGYPAM AAINARKMKF ALLKGSFSEQ GINEFLRELS FGRGSTAPVG GGAFPTIVER EPWDGRDGEL PVEDDIDLSD VELDDLGKDE L (1-440 aa encoded by BC001312)
靶标信息
P5 is a novel protein that was originally identified in humans. Functionally, P5 has been shown to have peptide binding ability and chaperone activity specific to certain proteins. P5 shares several structural similarities to PDI, an important protein of the ER. The deduced amino acid sequence of P5 shows that it contains the ER retention signal KDEL. P5 also contains two CXXC-like motifs, a motif responsible for oxidoreductase activity. These two CXXC motifs are found on the N- and C-terminus of the protein, one at each end. Studies suggest that the N-terminal CXXC motif is more important than the second for isomerase activity. Contrary to most of the PDI-like proteins, P5 is not stress-inducible.
仅用于科研。不用于诊断过程。未经明确授权不得转售。
生物信息学
蛋白别名: CaBP1; Calcium-binding protein 1; Endoplasmic reticulum protein 5; epididymis secretory sperm binding protein; ER protein 5; protein disulfide isomerase A6; protein disulfide isomerase associated 6; Protein disulfide isomerase P5; protein disulfide isomerase-associated 6; protein disulfide isomerase-related protein; Protein disulfide-isomerase A6; thioredoxin domain containing 7; thioredoxin domain containing 7 (protein disulfide isomerase); Thioredoxin domain-containing protein 7; unnamed protein product
基因别名: 1700015E05Rik; AL023058; C77895; CaBP1; CaBP5; ERP5; P5; PDIA6; TXNDC7
UniProt ID: (Human) Q15084, (Mouse) Q922R8, (Rat) Q63081
Entrez Gene ID: (Human) 10130, (Mouse) 71853, (Rat) 286906